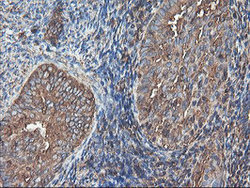

ABIN2672861
antibody from antibodies-online
Targeting: SENP2
AXAM2, DKFZp762A2316, KIAA1331, SMT3IP2
Antibody data
- Antibody Data
- Antigen structure
- References [0]
- Comments [0]
- Validations
- Western blot [1]
- Immunohistochemistry [8]
- Flow cytometry [2]
Submit
Validation data
Reference
Comment
Report error
- Product number
- ABIN2672861 - Provider product page

- Provider
- antibodies-online
- Product name
- anti-SUMO1/sentrin/SMT3 Specific Peptidase 2 (SENP2) (AA 139-523) antibody
- Antibody type
- Monoclonal
- Antigen
- Human recombinant protein fragment corresponding to amino acids 139-523 of human SENP2 (NP_067640) produced in E.coli.
- Description
- Purified from mouse ascites fluids by affinity chromatography
- Reactivity
- Human
- Host
- Mouse
- Epitope
- AA 139-523
- Isotype
- IgG
- Antibody clone number
- OTI6F1
- Vial size
- 100 μL
No comments: Submit comment
Supportive validation
- Submitted by
- antibodies-online (provider)
- Main image

- Experimental details
- Image(s): Western Blotting
Supportive validation
- Submitted by
- antibodies-online (provider)
- Main image

- Experimental details
- Image(s): Immunohistochemistry
- Submitted by
- antibodies-online (provider)
- Main image

- Experimental details
- Image(s): Immunohistochemistry
- Submitted by
- antibodies-online (provider)
- Main image

- Experimental details
- Image(s): Immunohistochemistry
- Submitted by
- antibodies-online (provider)
- Main image
- Experimental details
- Image(s): Immunohistochemistry
- Submitted by
- antibodies-online (provider)
- Main image

- Experimental details
- Image(s): Immunohistochemistry
- Submitted by
- antibodies-online (provider)
- Main image

- Experimental details
- Image(s): Immunohistochemistry
- Submitted by
- antibodies-online (provider)
- Main image

- Experimental details
- Image(s): Immunohistochemistry
- Submitted by
- antibodies-online (provider)
- Main image

- Experimental details
- Image(s): Immunohistochemistry
Supportive validation
- Submitted by
- antibodies-online (provider)
- Main image

- Experimental details
- Image(s): Flow cytometry
- Submitted by
- antibodies-online (provider)
- Main image

- Experimental details
- Image(s): Flow cytometry